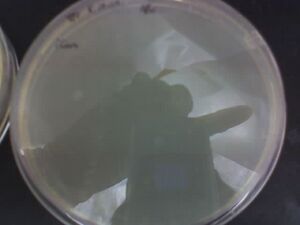

IGEM:Harvard/2006/Cyanobacteria/Notebook/2006-8-30
From OpenWetWare
Jump to navigationJump to search
Ligation Protocol I used
Go to our Protocols section, extensive writeup.
Ligation #6 Plates
Thousands of colonies! Excuse the blurriness, used my cameraphone :(

Note that for 2uL we got a lot more colonies than for 19uL. Means that the ligation mixture is toxic to the cells; do not use 19uL anymore for chemically competent cells!
Finally
Did a colony PCR of 36 colonies + positive control, streaking each on part of a KAN plate. 8uL PCR supermix, 1uL VF2 (2nM), 1uL VR (2nM).
It looks like we've finally succeeded in ligating J04500\SP + KaiC\XP!


Succesful ligations: V2 #4, V19 #1, #4, #5, #6, #7, M2 #7, M19 #2, #4, #8
Sequencing results for KaiB
... Don't make sense. Doing some AlignX work, shows that KaiB WITH biobricks prefix and suffix is in front of the J04500 promoter+RBS. Ideas?